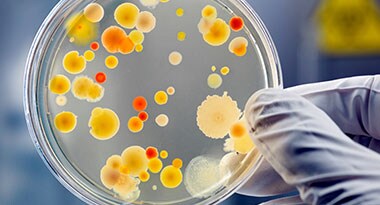
Culture Clear culture dish showing pathogens in medium

Search
Search

The global prevalence of sexually transmitted infections (STIs) is measured at more than 1 million new cases every day, most of which are asymptomatic. Accordingly, there are approximately 374 million new infections each year, which include three of the most common curable STIs: chlamydia, gonorrhea, and trichomoniasis [1]. These three STIs, as well as the bacterium Mycoplasma genitalium, can lead to complications including cervicitis, urethritis, preterm labor, and pelvic inflammatory disease (PID). They can also increase the risk of contracting HIV.
Research to better characterize and identify vaginal microbiota is also important for the health of women, their fetuses, and newborns. Globally, there are approximately 1 billion women affected each year by urogenital infections, including vaginitis. Bacterial vaginosis alone affects 21.2 million women annually and is the most common vaginal condition affecting women ages 15–44 [2]. This underscores the importance of detecting common prevalent STIs and vaginal pathogens to understand outbreaks and disease etiology.
This comprehensive STI infographic provides an overview of the causes and symptoms of many sexually transmitted infections, how they spread, its treatment, and testing technology.
Download Vaginal Health infographic
This comprehensive vaginal health infographic provides an overview of the causes and symptoms of many vaginal infections, how they spread, its treatment, and testing technology.
Click below to view Research Use Only (RUO) products for your molecular research needs.
For Research Use Only. Not for use in diagnostic procedures.
Find out more about our STI and vaginal health testing products and the benefits of molecular testing.
Bacteria | Virus | Fungus | Parasite |
Chlamydia trachomatis Mycoplasma genitalium Mycoplasma hominis Ureaplasma parvum Neisseria gonorrhoeae Ureaplasma urealyticum Gardnerella vaginalis Prevotella bivia Mobiluncus curtisii Pan-Lactobacillus Staphylococcus aureus Atopobium vaginae Megasphaera Type 1 (Mega 1) Bacteroides fragilis Bacterial vaginosis associated bacteria 2 (BVAB2) | Herpes simplex virus type 1 (HSV1) Herpes simplex virus type 2 (HSV 2) Cytomegalovirus Varicella zoster virus
| Pan-Candida Candida albicans Candida krusei Candida glabrata Candida dubliniensis Candida tropicalis Candida parapsilosis | Trichomonas vaginalis |
Diagnostic PCR (molecular) testing is considered the gold standard for pathogen detection and accuracy of results. The superior sensitivity of a molecular test can detect low pathogen loads. Molecular testing also has the benefit of scalability. Most lab-based PCR tests can accommodate 94 to 384 samples (including controls) simultaneously on a single plate.
Real-time PCR technology has significant advantages over other methods for identifying infectious disease pathogens. Traditional methods like culturing, immunodiagnostics, and microscopy can be inaccurate, subjective, or prone to contamination and often require repeat testing or reflex testing. Fastidious microorganisms often cannot be grown or detected using traditional methods, and long sample processing times can delay time-to-results. Molecular tests for relevant pathogens may be unavailable or lack flexibility.
Multiplex testing simultaneously differentiates sexually transmitted or vaginal diseases and helps identify cases of co-infection. Multiplex assay panels can go from two targets to dozens, making it an efficient technique.
A sample is sent to a lab where experts encourage organisms in the sample to multiply. Then they examine the dish to identify the pathogen.
Sample collection swabs are agitated in a pre-mixed solution and tested on a paper strip to return results within 30 minutes.
A blood sample collected from a syringe checks for the presence of antibodies against microorganisms
Genetic material from samples collected on swabs is amplified to detect genetic traces of a specific organism, even in early stages of infection.